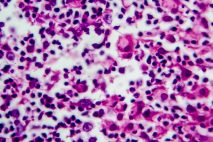

CHMP issues advice on the use of Celltrion’s regdanvimab (CT-P59) for COVID-19 patients in the European Union
Celltrion Group announced the European Medicines Agency’s (EMA) Committee for Medicinal Products for Human Use (CHMP) has issued a positive scientific opinion for the company’s anti-COVID-19 monoclonal antibody… read more.